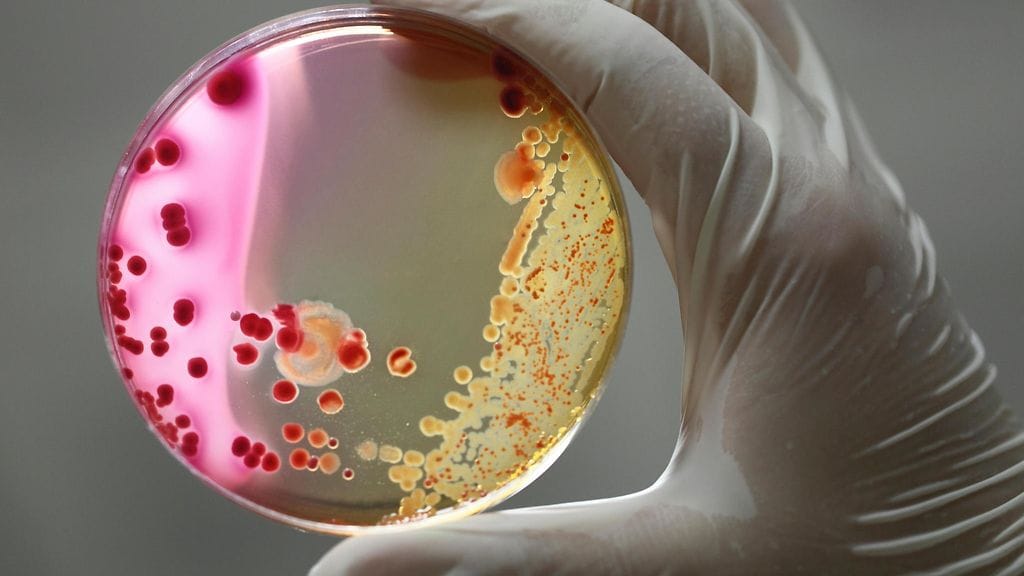

A-streptokokki eli lihansyöjäbakteeri on yleistynyt viime vuosina ja voi johtaa jopa kuolemaan. Yleensä se kuitenkin esiintyy angiinan ja tulirokon kaltaisessa lievemmässä muodossa.
A-streptokokki on yleinen bakteeri, jota iso osa ihmisistä kantaa nielussa tai iholla. Joka neljäs lapsi voi olla taudin kantaja. Aikuisistakin viitisen prosenttia kantaa tautia.
– Vakavampi muoto on yleistynyt. Ajatellaan, että se liittyy siihen, että yhdenlaista tyyppiä esiintyy nyt enemmän. Siltä se seurannassa näyttää. Tähän tyyppiin tiedetään liittyvän kohonnut riski vaikealle infektiolle, sanoo Terveyden- ja hyvinvoinninlaitoksen asiantuntijalääkäri Emmi Sarvikivi.
Tärkein keino torjunnassa on käsihygienia
Epidemia on kestänyt noin 2,5 vuotta. Siitä ollaan viisaampia tämän ja ensi vuoden aikana, mutta tällaisia huippuja on ollut ennenkin.
– Viimeksi 2007-2008 oli pienempi huippu, mutta seuraamme tilannetta ja katsomme mihin se kehittyy, Sarvikivi sanoo.
Lue myös: Tappaja- ja lihansyöjäbakteeriksikin kutsuttu tauti on jyllännyt Suomessa epidemiana 2,5 vuotta – vakavia A-streptokokkitapauksia viime vuonna enemmän kuin koskaan tartuntatautirekisterin olemassaolon aikana
A-streptokokki tarttuu pisaratartunnalla, käsien välityksellä eritteiden kautta tai iholla olevasta haavasta haavaeritteen kautta.